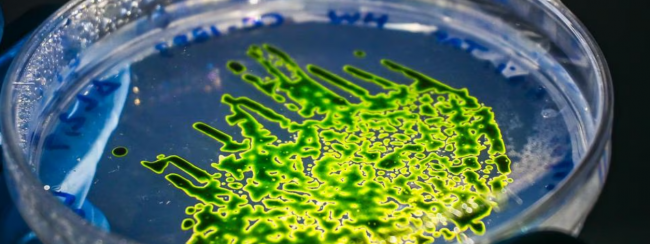
Miracle at the micro level

Mar
6
2026
Australia’s higher education sector is increasingly filled with talented and driven women: managing sprawling faculties, leading research across the span of disciplines, and taking on the job of running entire institutions. For her part, Nicola Phillips is just weeks into the top job at the newly-formed Adelaide University – a massive institution likely to soon …read more